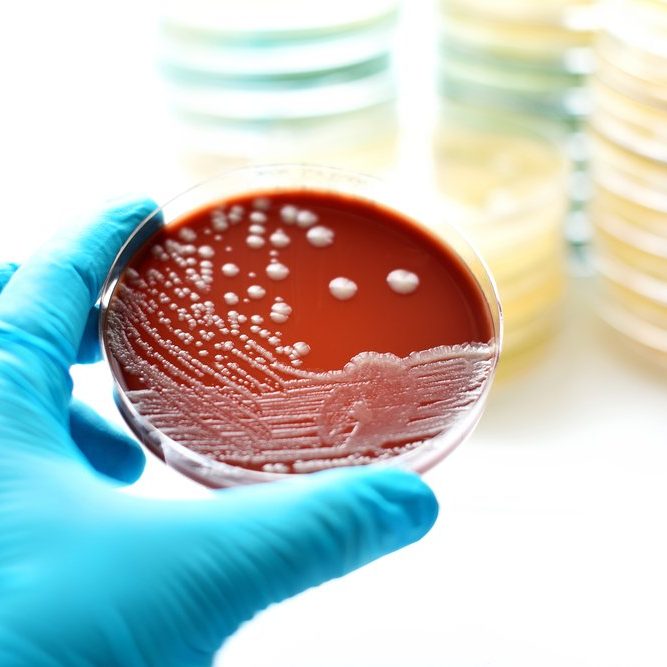
Pipework chlorination & disinfection to BS8558

Chlorination of Water Systems, Mains Water Pipework & Water Tanks
Pipework chlorination to BS8558.
JN Environmental Ltd are a specialist water treatment & testing company. Our qualified workforce covers all areas of the UK providing top-notch chlorination services for mains water pipework, water tanks, and water systems.
Your Trusted Water Treatment Supplier
At JN Environmental Ltd - Pipework Chlorination Services, we specialize in chlorination of water systems, mains water pipework, water tanks, and offer solutions for new, refurbished, and modified water systems. Our expert team ensures effective disinfection to combat stagnation and maintain water quality. Trust us for reliable and professional water treatment services.

Chlorination of Water Systems
A tried and tested method of disinfecting water systems and ensuring the eradication of dangerous pathogens such as Pseudomonas, Ecoli, and Legionella.
Expert Water Disinfection
Our team specializes in disinfection, cleaning and chlorination of water systems.
All of our engineers hold all the relevant City & Guilds qualifications.

New Water System Disinfection
Chlorination is required before a new or refurbished hot and cold water installation is brought into service.
Make sure your site remains compliant, contact us today.
Pipework Chlorination by JN Environmental Ltd
Your Partner in Water Treatment Solutions
JN Environmental is a reputable water treatment supplier dedicated to providing expert chlorination and disinfection solutions. JN Environmental can chlorinate new mains, existing water systems which have been modified and water tanks. We provide certificates of water analysis from UKAS accredited laboratories and chlorination certificates conforming to BS8558 on every job.
When is water chlorination needed?
There are several instances when a chlorination may be required on new or existing systems. These include:
System Contamination
If contamination is suspected or water analysis indicates microbial contamination then full cleaning and chlorination of the system should be carried out as soon as possible. A full system disinfection should also be carried out if a Legionnaire's Disease outbreak occurs.
New, modified or refurbished water systems
Chlorination is required before a new or refurbished water services installation is brought into service, this includes both hot and cold services.
System inactivity or stagnation
Chlorination should be carried out when the water services haven't been used regularly due to the potential for pathogens such as Legionella and Pseudomonas to contaminate the water system.
Legionella risk assessment recommends chlorination or cleaning
If a legionella risk assessment recommends chlorination of the water system this should be carried out as soon as possible, this could vary from a full mains injection to water tank cleaning and disinfection.
Where do we work?
Typical places that require chlorinations are:
- Office blocks
- Retail parks
- Hotels
- Holiday parks
- Commercial properties

Ready to Ensure Safe Water?
Take the first step towards clean and safe water supply. Reach out to our team for reliable chlorination and disinfection solutions tailored to your requirements.
Get in touch
National Head Office
Tel: 01615236357
E-mail: info@jnenvironmental.co.uk
Address: Unit 10 Peel Industrial Estate, Chamberhall Street, Bury, BL9 0LU, Lancashire
©Copyright. All rights reserved.
We need your consent to load the translations
We use a third-party service to translate the website content that may collect data about your activity. Please review the details in the privacy policy and accept the service to view the translations.
